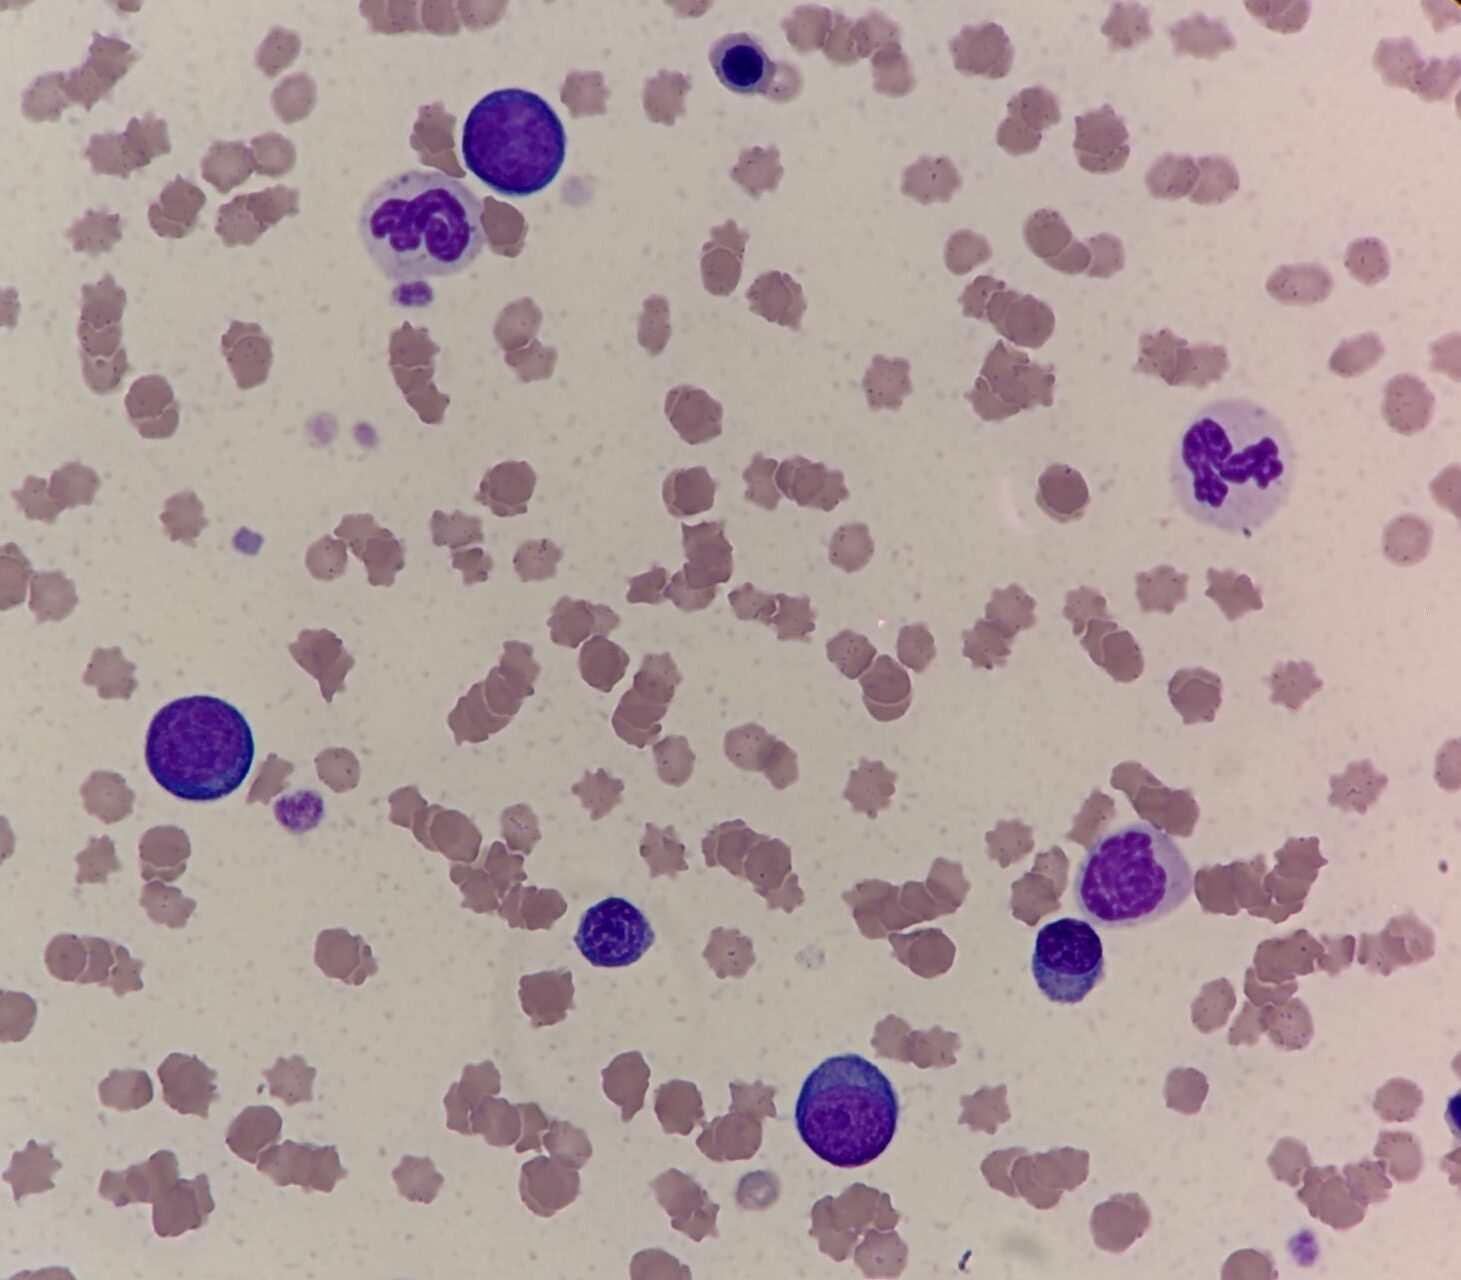
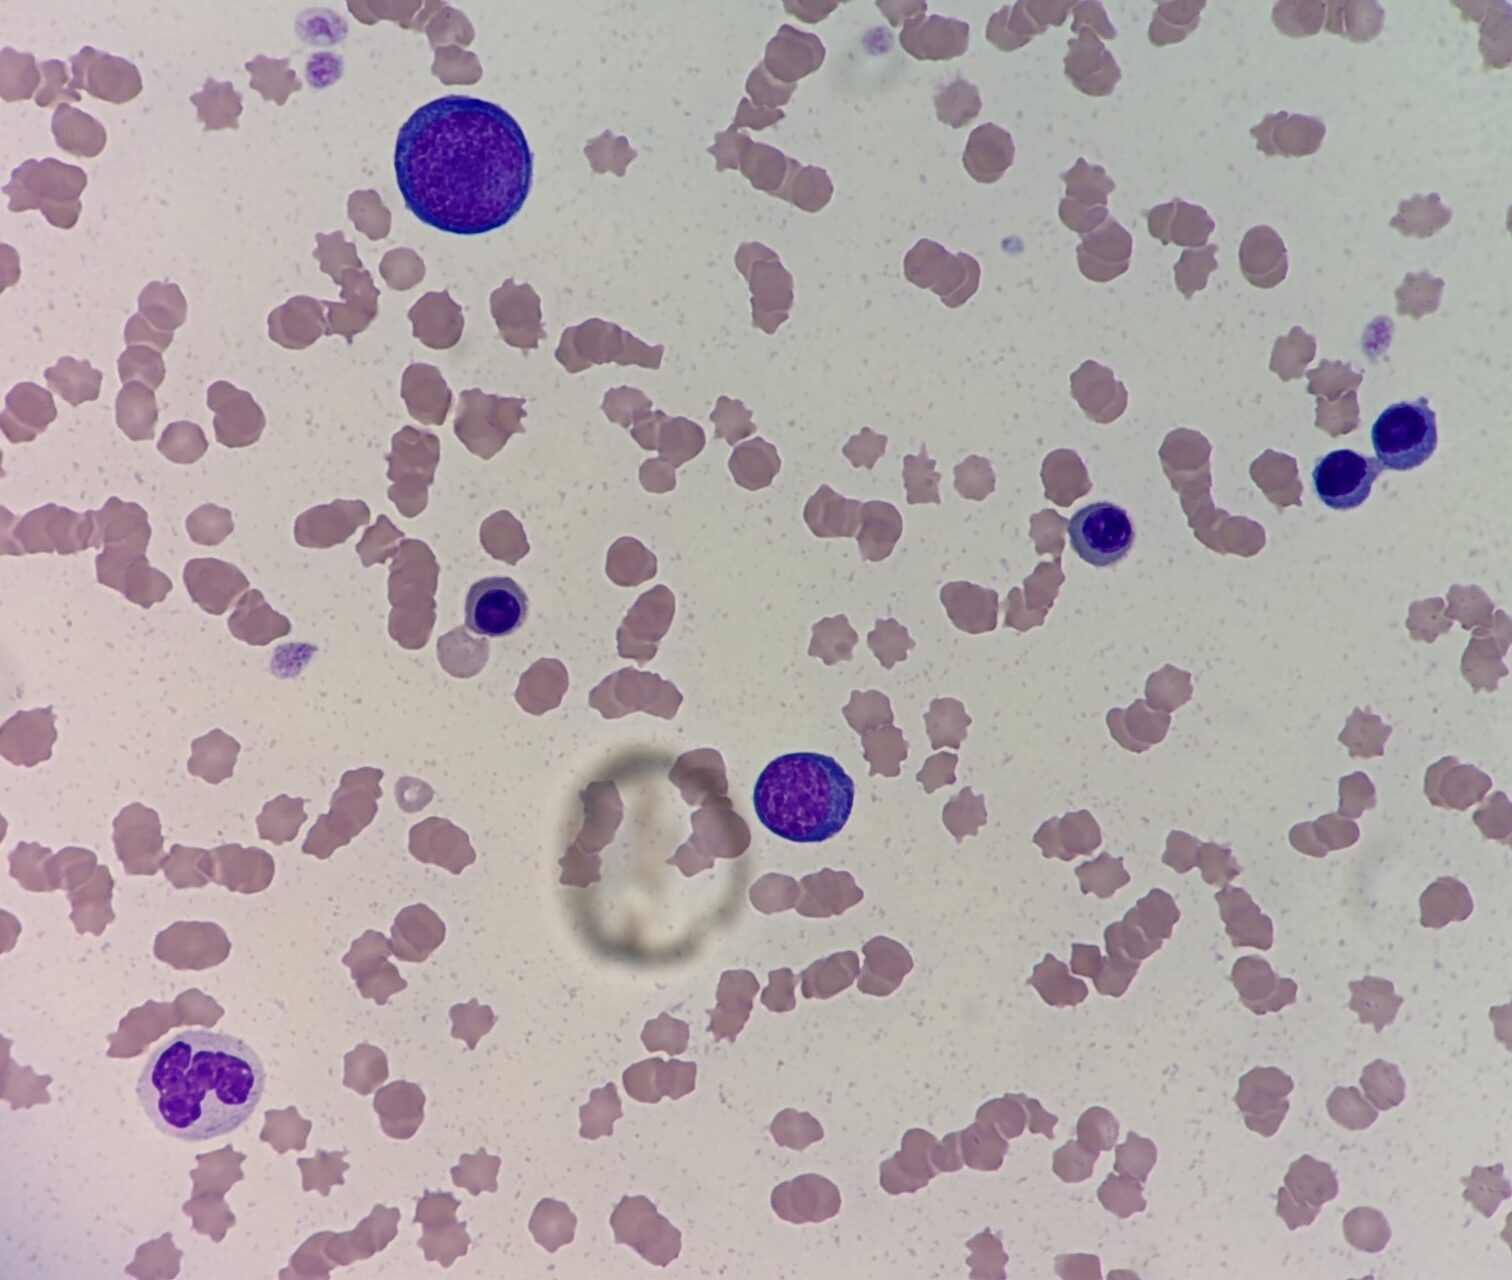
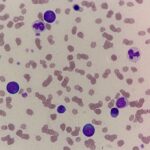

猫の急性白血病




高齢猫が貧血を主訴に紹介来院しました。
重度の貧血の原因には大きく分けて、出血、赤血球の破壊、骨髄疾患があります。
この患者さんでは赤血球を生み出す起源の細胞が血液中に出現していました。本来このような細胞が骨髄から末梢血中に出ることはなく腫瘍性(急性白血病)と診断しました。
残念ながら現在の獣医寮では白血病に対する有効な治療はなく、緩和ケアのみとなります。

高齢猫が貧血を主訴に紹介来院しました。
重度の貧血の原因には大きく分けて、出血、赤血球の破壊、骨髄疾患があります。
この患者さんでは赤血球を生み出す起源の細胞が血液中に出現していました。本来このような細胞が骨髄から末梢血中に出ることはなく腫瘍性(急性白血病)と診断しました。
残念ながら現在の獣医寮では白血病に対する有効な治療はなく、緩和ケアのみとなります。